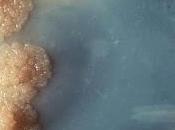
#thelancet #tuberculose #Mycobacteriumtuberculosis #ARN Signature d’expression l’ARN sanguin risque tuberculose

Tartempion77
MES BLOGS
-
Actualités Scientifiques - Médicales
http://actuscimed.com/
Ce blog propose des traductions adaptées en Français d'abstracts d'articles de science médicales, issus de revues de médecine et de science à facteur d'impact très élevé, tout récemment parus sur internet.
DERNIERS ARTICLES (1937)
-
#thelancet #insuffisancecardiaqueischémique #thérapiecellulaire #ixmyelocel...

Représentation schématique d'un coeur présentant un infarctus du myocarde (ischémie myocardique).Source iconographique et légendaire: http://www.inserm. Lire la suite
Publié le 06 avril 2016 MALADIES, SANTÉ, SOINS -
#thelancet #scorederisquedesaignement #fibrillationauriculaire #AVC Nouveau...

La fibrillation auriculaire est une maladie chronique qui résulte le plus souvent du vieillissement de l'oreillette (cavité supérieure du coeur). Au lieu de se... Lire la suite
Publié le 05 avril 2016 MALADIES, SANTÉ, SOINS -
#Cell #enzymed’éditiondel’arn #protéinedeliaisonàl’arn #TRIBE : Détournement d’u...

Une technique appelée TRIBE identifie les cibles cellulaires spécifiques des protéines de liaison à l’ARN, même sur une petite population de cellules, par la... Lire la suite
Publié le 04 avril 2016 MALADIES, SANTÉ, SOINS -
#thelancet #fibrosepulmonaireidiopathique #refluxgastrooesophagien...

Radiographie du poumon d'un patient atteint de fibrose pulmonaire idiopathique. On observe la petite taille des poumons et l'opacification réticulo-nodulaire... Lire la suite
Publié le 01 avril 2016 MALADIES, SANTÉ, SOINS -
#thelancetneurololgy #α-synucléine #troubledusommeil #maladiedeparkinson...

La polysomnographie est l'enregistrement complet du sommeil. Cet examen consiste à capter les rythmes électriques qui proviennent du corps pour en déduire les... Lire la suite
Publié le 31 mars 2016 MALADIES, SANTÉ, SOINS -
#trendsinendocrinologyandmetabolism #aberrationsgénomiques...

Options thérapeutiques pour le cancer de la prostate résistant à la castration selon les recommandations de l'AFU de 2010 et des connaissances actuelles... Lire la suite
Publié le 30 mars 2016 MALADIES, SANTÉ, SOINS -
#thelancetoncology #cancerdusein #chimiotherapieadjuvante #bevacizumab...

Mammographie montrant un cancer du sein à droite.Source iconographique et légendaire: https://fr.wikipedia.org/wiki/Cancer_du_seinL’adjonction de bevacizumab à... Lire la suite
Publié le 29 mars 2016 MALADIES, SANTÉ, SOINS -
#Cell #ARNm #introns #épissage #spliceosome #PolII L’épissage des ARNs...

Les stratégies de séquençage de deux molécules naissantes d’ARN simple brin montrent que l’épissage du pré-ARNm survient après son passage des introns, mettant... Lire la suite
Publié le 25 mars 2016 MALADIES, SANTÉ, SOINS -
#thelancet #tuberculose #Mycobacteriumtuberculosis #ARN Signature d’expression d...
Colonies bactériennes de Mycobacterium tuberculosis (bacille de Koch).Source: https://en.wikipedia.org/wiki/Mycobacterium_tuberculosis L’identification de... Lire la suite
Publié le 24 mars 2016 MALADIES, SANTÉ, SOINS -
#thelancethaematology #thromboembolismeveineux #edoxaban #warfarine Durée...

Exemple de thrombose veineuse superficielleSource: http://www.inserm.fr/espace-journalistes/la-thrombose-veineuse-superficielle-enfin-traiteeIl n’y a que peu... Lire la suite
Publié le 23 mars 2016 MALADIES, SANTÉ, SOINS -
#thelancet #tuberculose #migrants #royaumeuni Prévalence et facteurs de risque d...

Migrants en provenance du Pakistan abordant les rivages de l'île de Kos. Août 2015Source: http://www.bbc.co.uk/news/world-europe-34105989Un nombre croissant de... Lire la suite
Publié le 22 mars 2016 MALADIES, SANTÉ, SOINS -
#trendsinendocrinologyandmetabolism #insulinorésistance #PPARβ/γ Déchiffrage de...

Voies de signalisation PPAR - alpha et PPAR - gamma.Diet, adipose tissue = Régime alimentaire, tissu adipeuxCell membrane = Membrane cellulaireFatty acids =... Lire la suite
Publié le 21 mars 2016 MALADIES, SANTÉ, SOINS -
#Cell #neurones #sommeil #veille Le taux d’activation des neurones est inhibé pa...

Les circuits neuronaux sont stabilisés par des taux d’activation revenant à un point de consigne qui est spécifique aux neurones individuels, mais ce processus... Lire la suite
Publié le 18 mars 2016 MALADIES, SANTÉ, SOINS -
#thelancetdiabetesandendocrinology #transportactif #marche #cyclisme #obésité...

"Les Métamorphoses du gras " de Georges Vigarello est paru aux éditions du Seuil en mars 2010.Source iconographique et légendaire: http://rue89.nouvelobs. Lire la suite
Publié le 17 mars 2016 MALADIES, SANTÉ, SOINS -
#thelancet #viruszika #microcéphalie Association entre virus Zika et...

Le virus Zika se transmet d'homme à homme par le biais d'une piqûre de moustique Aedes. afp.com/RAUL ARBLOLEDASource iconographique et légendaire:... Lire la suite
Publié le 16 mars 2016 MALADIES, SANTÉ, SOINS -
#thelancethiv #VIH-1 #emtricitabine #tenofoviralafenamide...

Lymphocytes infectés par le VIH-1. Les particules virales (en jaune) bourgeonnent à la surface d'une cellule infectée. Image réalisée en microscopie électroniqu... Lire la suite
Publié le 15 mars 2016 MALADIES, SANTÉ, SOINS -
#trendsincellbiology #golgi #superhélice #golgine À la recherche de l’appareil ...
L'appareil de Golgi comprend de multiples sacs aplatis qui forment des citernes. Il assure la réception , la modification, le triage, l'emballage, et... Lire la suite
Publié le 14 mars 2016 MALADIES, SANTÉ, SOINS -
#Cell #TMAO microbesintestinaux #plaquettes #thrombose Le métabolite microbien...

Le métabolite microbe-dépendant de l’intestin TMAO agit directement sur l’augmentation de l’hyperréactivité plaquettaire et le potentiel de thrombose in vivo,... Lire la suite
Publié le 11 mars 2016 MALADIES, SANTÉ, SOINS -
#trendsinendocrinologyanddiabetes #diabètedetype2 #complicationsurologiques...

La metformine est - au départ - un médicament hypoglycémiant administré chez les patients souffrant de diabète de type 2Source iconographique:... Lire la suite
Publié le 10 mars 2016 MALADIES, SANTÉ, SOINS -
#thelancetinfectiousdiseases #mucormycose #isavuconazole #amphotéricineB...

L'oeil et la zone orbitaire sont souvent touchés en cas de mucormycose / Cliché Dr. Thomas F Sellers/Emory UniversitySource iconographique et légendaire:... Lire la suite
Publié le 09 mars 2016 MALADIES, SANTÉ, SOINS
